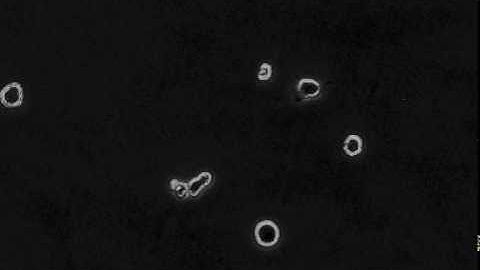
Microglia cell migration

⬇ DOWNLOAD NOW
Kalau muncul iklan pop-up, tutup lalu klik tombol kembali
Download lagu Microglial cell migrating through live mouse brain parenchyma. secara gratis hanya untuk keperluan promosi. Dukung artis favorit kamu dengan membeli musik original di iTunes atau platform resmi lainnya.
 Glioma Cell Migration Dynamics in Brain Tissue Assessed by Multimodal Optical Imaging
Glioma Cell Migration Dynamics in Brain Tissue Assessed by Multimodal Optical Imaging
Microglia cell migration
Microglia cell migration
 Visualizing Microglia in Whole-Tissue Cleared Mouse Brain
Visualizing Microglia in Whole-Tissue Cleared Mouse Brain
 Microglia processes turning to injury
Microglia processes turning to injury
 Microglia cell roaming through the brain
Microglia cell roaming through the brain
 Microglial_phagocytosis_dead_cell
Microglial_phagocytosis_dead_cell
 Migrating neuronal cells
Migrating neuronal cells
 glia.mov
glia.mov